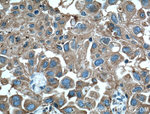
LAMP2 Antibody in Immunohistochemistry (Paraffin) (IHC (P))
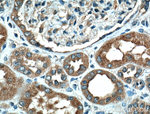
LAMP2 Antibody in Immunohistochemistry (Paraffin) (IHC (P))
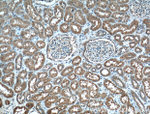
LAMP2 Antibody in Immunohistochemistry (Paraffin) (IHC (P))

Search
Proteintech
LAMP2 Monoclonal Antibody (2D3B9)
{{$productOrderCtrl.translations['antibody.pdp.commerceCard.promotion.promotions']}}
{{$productOrderCtrl.translations['antibody.pdp.commerceCard.promotion.viewpromo']}}
{{$productOrderCtrl.translations['antibody.pdp.commerceCard.promotion.promocode']}}: {{promo.promoCode}} {{promo.promoTitle}} {{promo.promoDescription}}. {{$productOrderCtrl.translations['antibody.pdp.commerceCard.promotion.learnmore']}}
产品信息
66301-1-IG
种属反应
已发表种属
宿主/亚型
分类
类型
克隆号
抗原
偶联物
形式
浓度
规格
纯化类型
保存液
内含物
保存条件
运输条件
产品详细信息
Immunogen sequence: NPNTTHSTG SCRSHTALLR LNSSTIKYLD FVFAVKNENR FYLKEVNISM YLVNGSVFSI ANNNLSYWDA PLGSSYMCNK EQTVSVSGAF QINTFDLRVQ PFNVTQGKYS TAQECSLDDD TILIPIIVGA GLSGLII (255-390 aa encoded by BC002965 )
靶标信息
LAMP2 (Lysosome-associated membrane glycoprotein 2, CD107b) is a member of a family of membrane glycoproteins. LAMP2 provides selectins with carbohydrate ligands, and may play a role in tumor cell metastasis, and have a function in the protection, maintenance, and adhesion of the lysosome. Prior to posttranslational modification, LAMP2 is approximately 46 kDa polypeptide. Mature, functional LAMP2 is extensively glycosylated with a variety of different N-linked and O-linked oligosaccharides with a total molecular weight of about 100-130 kDa. LAMP 2 has a structure comprised of a large amino-terminal intra-lysosomal domain, a hydrophobic trans-membrane domain, and a short carboxyl-terminal cytoplasmic tail. LAMP2 is used to monitor a very selective form of autophagy called chaperone-mediated autophagy. LAMP 2 has a structure comprised of a large amino-terminal intra-lysosomal domain, a hydrophobic trans-membrane domain, and a short carboxyl-terminal cytoplasmic tail. The LAMP protein has 3 variant forms: LAMP-2A, -2B, and 2C. LAMP2, together with CD107a/LAMP-1, is a major constituent of lysosomal membrane. The LAMP proteins are involved in lysosome biogenesis and are required for fusion of lysosomes with phagosomes, and LAMP2 is an important regulator in successful phagosomal maturation. LAMP2 deficiency causes an accumulation of autophagosomes in many tissues leading to cardiomyopathy and myopathy (Danon's disease).
仅用于科研。不用于诊断过程。未经明确授权不得转售。
生物信息学
蛋白别名: CD107 antigen-like family member B; CD107b; Igp96; LAMP-2; LAMP-2 Isoform 2A; LAMP-2 Variant A; LAMP-2C; LGP-96; LGP-B; lysosomal membrane glycoprotein 2; Lysosomal membrane glycoprotein type B; Lysosome-associated membrane glycoprotein 2; RP23-193O17.2; unnamed protein product
基因别名: CD107b; DND; Lamp II; LAMP-2; Lamp-2a; Lamp-2b; Lamp-2c; LAMP2; LAMPB; LGP-96; LGP-B; LGP110; Mac3
UniProt ID: (Human) P13473, (Mouse) P17047
Entrez Gene ID: (Pig) 100154598, (Human) 3920, (Mouse) 16784